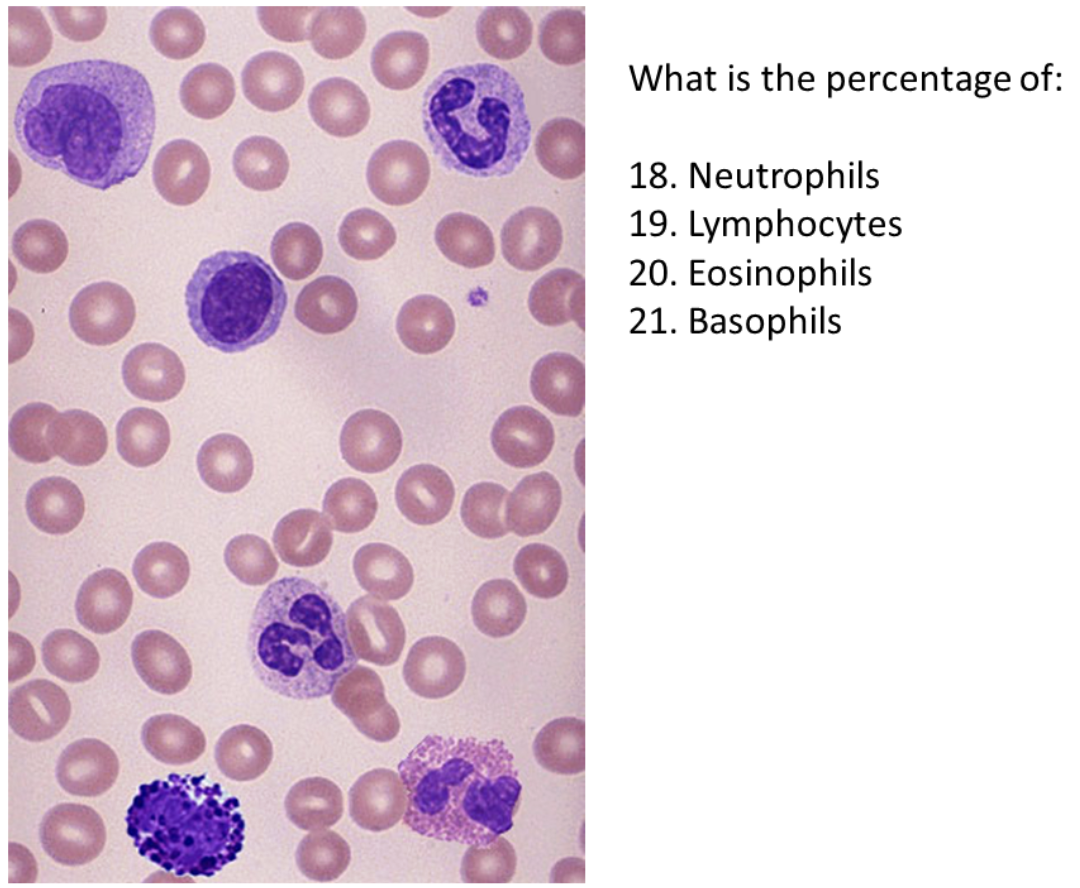
<p>What is the percentage of Eosinophils</p>

A&P II LAB PRACTICUM (MIDTERM)
1/147
There's no tags or description
Looks like no tags are added yet.
Name | Mastery | Learn | Test | Matching | Spaced | Call with Kai |
|---|
No analytics yet
Send a link to your students to track their progress
148 Terms

Identify 1
Thyroid Gland

Identify 2
Testis

Identify 3
Adrenal Gland

Identify 4
Ovary

Identify 5
Thymus Gland

Identify 6
Adrenal Gland

Identify 7
Eosinophils

Identify 8
Monocyte

Identify 9
Neutrophils

Identify 10
Red Blood Cell

Identify 11
Platelets

Identify 12
Basophils

Identify 13
Lymphocytes

What is the percentage of Neutrophils
5/15 = 33%

What is the percentage of Lymphoctyes
3/15 = 20%

What is the percentage of Eosinophils
3/15 = 20%

What is the percentage of Basophils
1/15 = 6.6% or 7%

What is the percentage of Neutrophils
2/6 = 33%

What is the percentage of Lympphocytes
1/6 = 17%
What is the percentage of Eosinophils
1/6 = 17%

What is the percentage of Basophils
1/6 = 17%

Identify 22
Superior Vena Cava

Identify 23
Aorta

Identify 24
Pulmonary Semilunar Valve

Identify 25
Pulmonary Trunk

Identify 26
Ligamentum Arteriosum

Identify 27
Left Pulmonary Vein

Identify 28
Left Atrium

Identify 29
Bicuspid Valve

Identify 30
Tricuspid Valve

Identify 31
Right Ventricle

Identify 32
Apex

Identify 33
Superficial Temporal Artery

Identify 34
External Jugular Vein

Identify 35
Internal Jugular Vein

Identify 36
L Common Corotid Artery

Identify 37
Right Subclavian Artery

Identify 38
Superior Vena Cava

Identify 39
Aortic Arch

Identify 40
Cephalic Vein

Identify 41
Brachial Artery

Identify 42
Basilic Vein

Identify 43
Median Cubital Vein

Identify 44
Radial Artery

Identify 45
Left External Iliac Vein

Identify 46
Gonadal Artery

Identify 47
Right Internal Common Iliac Vein

Identify 48
Inferior Mesenteric Artery

Identify 49
Renal Artery

Identify 50
Splenic Artery

Identify 51
Celiac Trunk

Identify 52
Hepatic Artery

Identify 53
Right Common Iliac Artery

Identify 54
O+

Identify 55
O-

Identify 56
B-

Identify 57
AB+

Identify 58
AB-

List Compatible Donors for O+
O+, O-

List Compatible Donors for O-
O-

List Compatible Donors for A+
O+, O-, A+, A-

List Compatible Donors for A-
O-, A-

List Compatible Donors for B+
O+, O-, B+, B-
List Compatible Donors for B-
O-, B-
List Compatible Donors for AB+
ALL
List Compatible Donors for AB-
O-, B-, A-, AB-

Identify 64
Tunica Media

Identify 65
Tunica Externa

Identify 66
Nerve

Identify 67
Artery

Identify 68
Vein

Identify 69
Esophagus

Identify 70
Larynx

Identify 71
Epiglottis

Identify 72
Oropharynx

Identify 73
Uvula

Identify 74
Hard Palate

Identify 75
Inferior Nasal Conchae (filter air)

Identify 76
Nose

Identify 77
Larynx

Identify 78
Trachea

Identify 79
Right Primary Bronchus

Identify 80
Secondary Bronchus

Identify 81
Horizontal Fissure

Identify 82
Parietal Pleura

Identify 83
Diaphragm

Identify 84
Left Superior Lobe

Identify 85
Left Inferior Lobe

Identify 86
Right Middle Lobe

Identify 87
Vein

Identify 88
Artery

Identify 89
Tunica Externa

Identify 91
QRS Complex

Identify 90
P wave

Identify 92
S-T Segment

Identify 93
T Wave

Identify 100
Plasma

Identify 101
Buffy Coat

Identify 102
Packed Cell Layer

Identify tubes that may indicate Dehydration
Tube 105 (High RBCs)